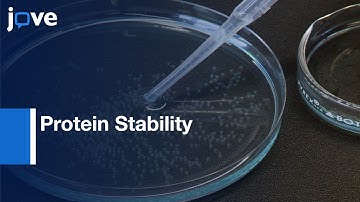
FDAP for Protein Stability Measurement | Protocol Preview

⬇ DOWNLOAD NOW
Jika muncul iklan pop-up, tutup lalu klik tombol kembali
Download lagu Maximizing Data Capture for Protein Thermal Stability with UV-Vis Analyses secara gratis hanya untuk keperluan promosi. Dukung artis favorit kamu dengan membeli musik original di iTunes atau platform resmi lainnya.
 The Science of Heat Shock Proteins in Proteostasis
The Science of Heat Shock Proteins in Proteostasis Discover the cutting-edge proteomics technology at the NBCC
Discover the cutting-edge proteomics technology at the NBCC Ubiquitin-Proteasome System | Targeted Protein Degradation
Ubiquitin-Proteasome System | Targeted Protein Degradation Cary UV Vis Video
Cary UV Vis Video 애질런트 Cary 3500 UV-Vis 분광 광도계 - 고속 스펙트럼 스캔 가능
애질런트 Cary 3500 UV-Vis 분광 광도계 - 고속 스펙트럼 스캔 가능 Detecting Proteins at 280 nm by UV-Vis: Why? How?
Detecting Proteins at 280 nm by UV-Vis: Why? How? Understanding protein stability
Understanding protein stability FDAP for Protein Stability Measurement | Protocol Preview
FDAP for Protein Stability Measurement | Protocol Preview